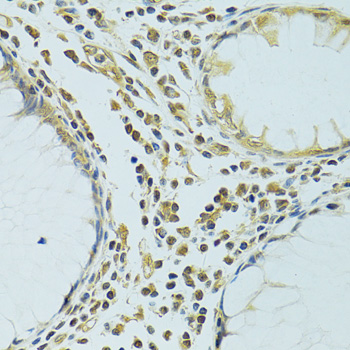
Immunohistochemistry - METTL13 Polyclonal Antibody

-
Product Name
METTL13 Polyclonal Antibody
- Documents
-
Description
Polyclonal antibody to METTL13
-
Tested applications
WB, IHC, IF
-
Species reactivity
Human
-
Alternative names
METTL13 antibody; 5630401D24Rik antibody; CGI-01 antibody; KIAA0859 antibody; feat antibody; methyltransferase like 13 antibody
-
Isotype
Rabbit IgG
-
Preparation
Antigen: Recombinant fusion protein containing a sequence corresponding to amino acids 430-699 of human METTL13 (NP_057019.3).
-
Clonality
Polyclonal
-
Formulation
PBS with 0.02% sodium azide, 50% glycerol, pH7.3.
-
Storage instructions
Store at -20℃. Avoid freeze / thaw cycles.
-
Applications
WB 1:500 - 1:2000
IHC 1:50 - 1:100
IF 1:50 - 1:100 -
Validations

Western blot - METTL13 Polyclonal Antibody
Western blot analysis of extracts of MCF7 cells, using METTL13 antibody at 1:1000 dilution.Secondary antibody: HRP Goat Anti-Rabbit IgG (H+L) at 1:10000 dilution.Lysates/proteins: 25ug per lane.Blocking buffer: 3% nonfat dry milk in TBST.Detection: ECL Enhanced Kit .Exposure time: 30s.
Immunohistochemistry - METTL13 Polyclonal Antibody
Immunohistochemistry of paraffin-embedded human colon using METTL13 antibody at dilution of 1:100 (40x lens).

Immunohistochemistry - METTL13 Polyclonal Antibody
Immunohistochemistry of paraffin-embedded human breast cancer using METTL13 antibody at dilution of 1:100 (40x lens).

Immunofluorescence - METTL13 Polyclonal Antibody
Immunofluorescence analysis of A549 cells using METTL13 antibody . Blue: DAPI for nuclear staining.
-
Background
Dual methyltransferase that catalyzes methylation of elongation factor 1-alpha (EEF1A1 and EEF1A2) at two different positions, and is therefore involved in the regulation of mRNA translation. Via its C-terminus, methylates EEF1A1 and EEF1A2 at the N-terminal residue 'Gly-2'. Via its N-terminus dimethylates EEF1A1 and EEF1A2 at residue 'Lys-55'.
Related Products / Services
Please note: All products are "FOR RESEARCH USE ONLY AND ARE NOT INTENDED FOR DIAGNOSTIC OR THERAPEUTIC USE"
